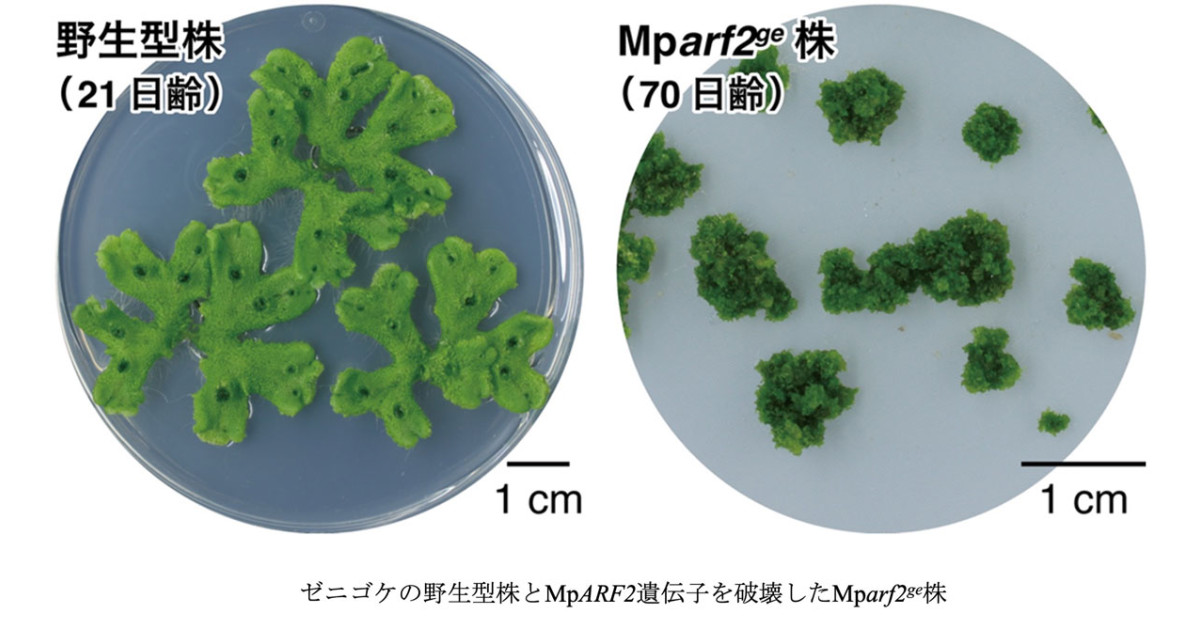
植物の永続的な成長を支える分子機構を解明～成長点の司令塔を担う転写

マイストア
変更
お店で受け取る
(送料無料)
配送する
納期目安:
2025.12.30 2:50頃のお届け予定です。
決済方法が、クレジット、代金引換の場合に限ります。その他の決済方法の場合はこちらをご確認ください。
※土・日・祝日の注文の場合や在庫状況によって、商品のお届けにお時間をいただく場合がございます。
【にこにこ植物】速達 コケそうじ ゼニゴケ専用濃縮液|種(タネ),球根,苗,資材の詳細情報
コケそうじ ゼニゴケ専用濃縮液|種(タネ),球根,苗,資材。植物の永続的な成長を支える分子機構を解明~成長点の司令塔を担う転写。楽天市場】ニゲラ(ラブインアミスト) 【有機ハーブ種子】【固定種。ニコ様専用 ニコニコ様専用 にこにこ^_^さま♥️専用 にこにこ様専用 (。(特価ジェイドガール、バクテリア、ベイチー、レガレ、クラリネルビウム)ホワイトモンスター、ミント速達
ベストセラーランキングです
近くの売り場の商品
カスタマーレビュー
オススメ度 4.4点
現在、6084件のレビューが投稿されています。